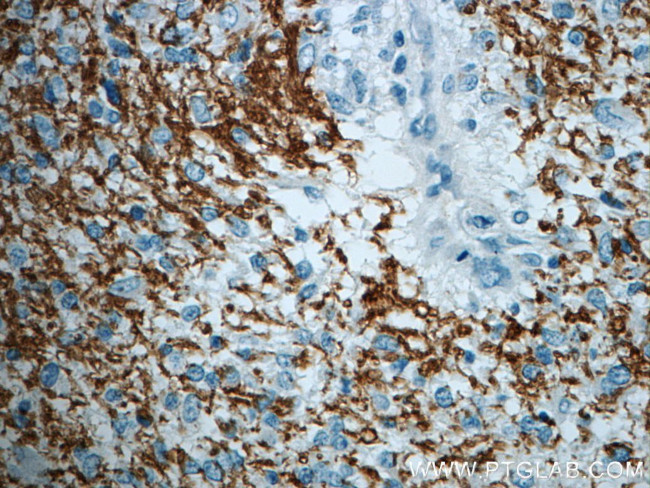
ROBO3 Antibody in Immunohistochemistry (Paraffin) (IHC (P))

Search
Proteintech
ROBO3 Polyclonal Antibody
{{$productOrderCtrl.translations['antibody.pdp.commerceCard.promotion.promotions']}}
{{$productOrderCtrl.translations['antibody.pdp.commerceCard.promotion.viewpromo']}}
{{$productOrderCtrl.translations['antibody.pdp.commerceCard.promotion.promocode']}}: {{promo.promoCode}} {{promo.promoTitle}} {{promo.promoDescription}}. {{$productOrderCtrl.translations['antibody.pdp.commerceCard.promotion.learnmore']}}
产品信息
20220-1-AP
种属反应
宿主/亚型
分类
类型
抗原
偶联物
形式
浓度
规格
纯化类型
保存液
内含物
保存条件
运输条件
产品详细信息
The antibody is specific to ROBO3.
靶标信息
This gene is a member of the Roundabout (ROBO) gene family that controls neurite outgrowth, growth cone guidance, and axon fasciculation. ROBO proteins are a subfamily of the immunoglobulin transmembrane receptor superfamily. SLIT proteins 1-3, a family of secreted chemorepellants, are ligands for ROBO proteins and SLIT/ROBO interactions regulate myogenesis, leukocyte migration, kidney morphogenesis, angiogenesis, and vasculogenesis in addition to neurogenesis. This gene, ROBO3, has a putative extracellular domain with five immunoglobulin (Ig)-like loops and three fibronectin (Fn) type III motifs, a transmembrane segment, and a cytoplasmic tail with three conserved signaling motifs: CC0, CC2, and CC3 (CC for conserved cytoplasmic). Unlike other ROBO family members, ROBO3 lacks motif CC1. The ROBO3 gene regulates axonal navigation at the ventral midline of the neural tube. In mouse, loss of Robo3 results in a complete failure of commissural axons to cross the midline throughout the spinal cord and the hindbrain. Mutations ROBO3 result in horizontal gaze palsy with progressive scoliosis (HGPPS); an autosomal recessive disorder characterized by congenital absence of horizontal gaze, progressive scoliosis, and failure of the corticospinal and somatosensory axon tracts to cross the midline in the medulla.
仅用于科研。不用于诊断过程。未经明确授权不得转售。
生物信息学
蛋白别名: axon guidance receptor; FLJ21044; retinoblastoma inhibiting gene 1; Retinoblastoma-inhibiting gene 1 protein; Rig-1; Roundabout guidance receptor 3; Roundabout homolog 3; roundabout, axon guidance receptor, homolog 3; Roundabout-like protein 3; unnamed protein product
基因别名: HGPPS; HGPPS1; HGPS; RBIG1; Rig-1; RIG1; ROBO3; Robo3a; Robo3b
UniProt ID: (Human) Q96MS0, (Mouse) Q9Z2I4
Entrez Gene ID: (Human) 64221, (Rat) 315564, (Mouse) 19649